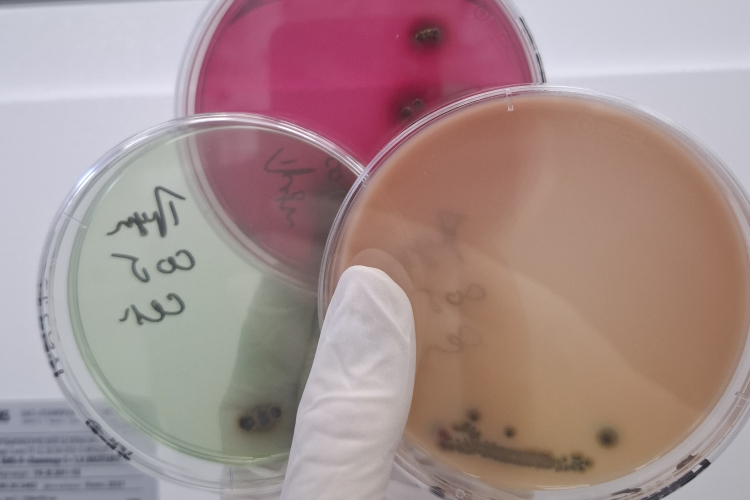
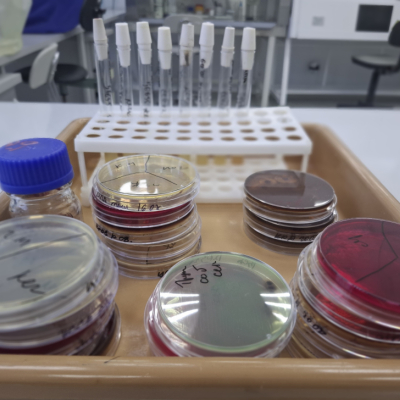
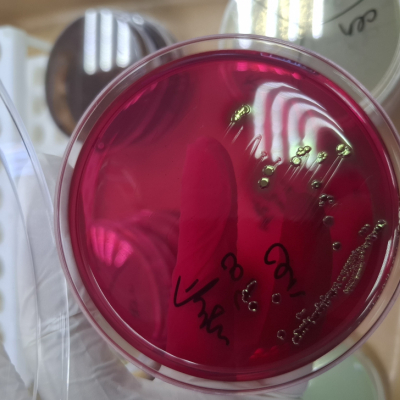
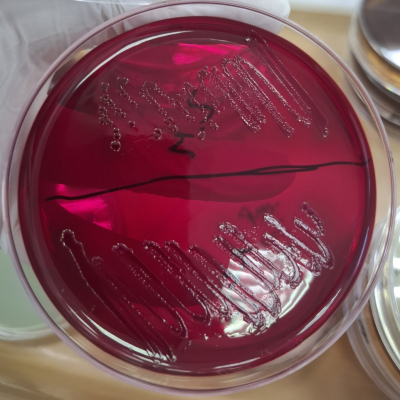

В отдел бактериологии, паразитологии и питательных сред Краснодарской испытательной лаборатории ФГБУ «ВНИИЗЖ» волонтёрами доставлен труп бездомной собаки в возрасте 7 лет. Животное не вакцинировано, не чипировано - предполагается отравление. Попутно поступил запрос на бактериологическое исследование, чтобы комплексно установить возможную причину гибели собаки.
При бактериологическом исследовании доставленного материала обнаружены возбудители смешанной кишечной инфекции: культуры Escherichia coli (08) и Citrobacter freundii. Патогенность культур или способность вызвать заболевание подтверждена биологической пробой, а также типированием специальными диагностическими сыворотками для установления серотипа выделенной кишечной палочки.
Смешанная кишечная инфекция – остропротекающая инфекционная болезнь молодняка разных видов животных. Вызывается двумя – тремя и более видами патогенных энтеробактерий, относящихся к родам Escherichia, Citrobacter, Proteus, Morganella и др. Помимо указанных микроорганизмов возбудителями болезни могут быть также бактерии других родов и семейств – Staphylococcus, Streptococcus, Pseudomonas и пр. Наряду с бактериальными культурами болезнь нередко обуславливают корона – и ротавирусы.
Часто у домашних животных возникают заболевания, имеющие инфекционную природу. Возбудителями могут выступать патогенные и условно-патогенные (т.е. способные при определенных условиях вызвать заболевание у животного) бактерии, вирусы, грибы и пр. Бактериальные инфекции у собак развиваются вне зависимости от возраста и породы, но зачастую им подвержены щенки с еще не сформировавшимся или ослабленным иммунитетом, старые, беременные животные, содержащиеся в неблагоприятных условиях, получающие несбалансированное питание.
Клиническая картина кишечных инфекций может быть ярко выражена, а может быть стерта или вовсе протекать бессимптомно. Частыми признаками кишечной инфекции выступают диарея, рвота, тошнота, бледность кожи и слизистых оболочек, потеря аппетита, апатия, повышенная температура тела, но не всегда. При отсутствии правильного лечения может наступить гибель животного вследствие поражения дыхательного и сердечно-сосудистого центров в продолговатом мозге вследствии воздействия на них бактериальных токсинов.
Кроме того, больное животное может являться источником инфекции для других животных и в первую очередь для владельцев. Поэтому так важно своевременно обратиться к ветеринарным специалистам для обследования, правильной установки причины заболевания и эффективного лечения. Ведь давно известно, что половиной успеха в купировании заболевания является точная диагностика.
Диагноз на смешанную кишечную инфекцию устанавливается после проведения лабораторных исследований. Для посмертной бактериологической диагностики вследствие сомнений в правильности назначенного лечения, а также для эффективного лечения других животных, контактировавших с павшим, в лабораторию направляют свежий труп умершего животного. Для прижизненной диагностики направляют свежие фекалии от больных животных.
Лечение проводят чувствительными к выделенным бактериям антибиотиками в сочетании с пробиотиками. В зависимости от выданной в лаборатории антибиотикограммы ветеринарный специалист назначает этиотропную терапию, непосредственно влияющую на возбудителя.
Для профилактики требуется соблюдать опти¬мальные условия содержания и кормления животных, не допуская дисбаланса микрофлоры кишечника.
Если вы встретили бродячих собак, которых нужно отловить или которые нуждаются в помощи, можно обратиться в органы местного самоуправления или ветеринарные службы. Для помощи бездомным собакам в Краснодаре, можно поддержать местные приюты и организации через пожертвования или волонтерскую помощь. Также можно взять животное на передержку, помочь с кормом или лекарствами, или взять собаку домой на постоянное содержание.
Специалисты отдела бактериологии, паразитологии и питательных сред Краснодарского филиала ФГБУ «ВНИИЗЖ» готовы оказать содействие в проведении бактериологических исследований, а также подобрать наиболее чувствительные препараты к каждому возбудителю для своевременного проведения лечения животных. Мы рады Вам помочь!